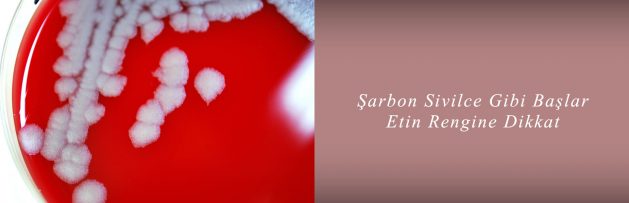

Şarbon Sivilce Gibi Başlar… Etin Rengine Dikkat
3 Eylül 2018
Koç Üniversitesi Tıp Fakültesi, İnfeksiyon Hastalıkları ve Klinik Mikrobiyoloji Bölümü’nden Prof. Dr. Önder Ergönül, şarbonun insandan insana bulaşma ihtimalinin çok düşük olduğunu söyledi.
Deri şarbonunun daha az riskli ancak bağırsak ve akciğer şarbonu denilen türlerinin çok daha tehlikeli olduğunu belirten Ergönül, şöyle konuştu: “Şarbon Türkiye’de özellikle Doğu ve Güneydoğu Anadolu bölgelerinde görülebilen hastalık. Silivri’de görülmüş olması ilginç. Bu hastalık deriyi tutan, nadiren solunum yolu ve yiyeceklerle de bulaşabilen bir hastalık. Örneğin o eti yedik ve hastalık geçti. Mide asidinde yok edilebilir ya da edilemez ve solunum yolu ile bulaşır. Ya da diyelim bir hayvan hastalıklı ve doğum yaptırıyorsunuz. O anda da küçük parçacıklar havaya salınır ve solunum yoluyla akciğere bulaşır. Öldürücü olabilir. Hastalık sivilce gibi başlar, büyür, kararır ve etrafında şişlikler oluşur. Başlangıç aşamasında fark edilirse antibiyotik tedavisi yeterli olabilir. Geç kalınır, özellikle de boyun kısmında görülürse antibiyotiğin yanı sıra pansumanlı, yatarak tedavi gerekebilir. Kişi nefes almakta da güçlük çeker. Kuluçka süresi 2-21 gündür. Erken teşhis için ilk hafta önemlidir.”
ETİN RENGİNE DİKKAT
Haber İçin [Tıklayınız]